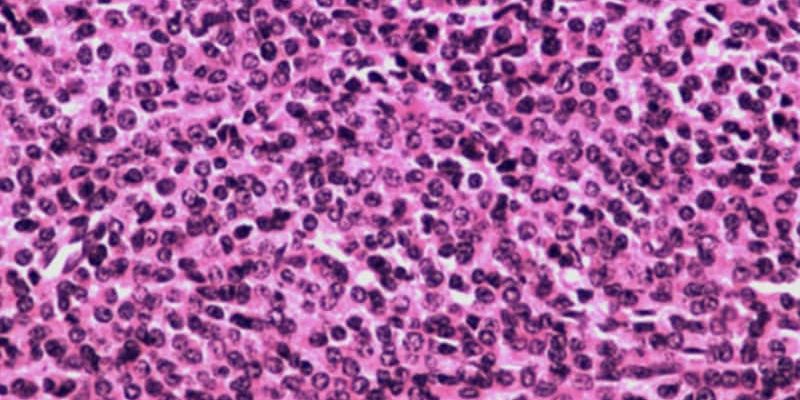
Das Isatuximab-4-Arzneimittel-Regime steigert die MRD-Negativität

Die Vierfachkombination des monoklonalen Anti-CD38-Antikörpers Isatuximab mit einer Grundtherapie aus Carfilzomib, Lenalidomid und Dexamethason (IsaKRd) zeigte eine signifikante Verbesserung der Ergebnisse der messbaren Resterkrankung (MRD) bei der Behandlung neu diagnostizierter Patienten mit ...
READ MORE +








